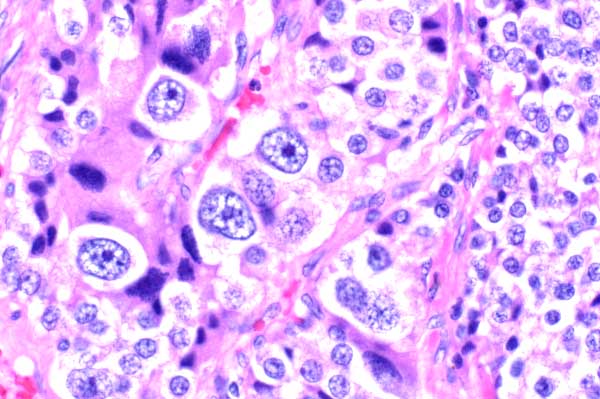

| 40x | Hematoxylin and Eosin | ||||
| Close Window | Macro View | Back | ||
|
There is prominent anisocytosis and anisokaryosis, with rare cells having large nuclei with vesiculate chromatin and a large nucleolus.
|
||||
|
|
||||
| Return | ||||
|
There is prominent anisocytosis and anisokaryosis, with rare cells having large nuclei with vesiculate chromatin and a large nucleolus.
|
||||